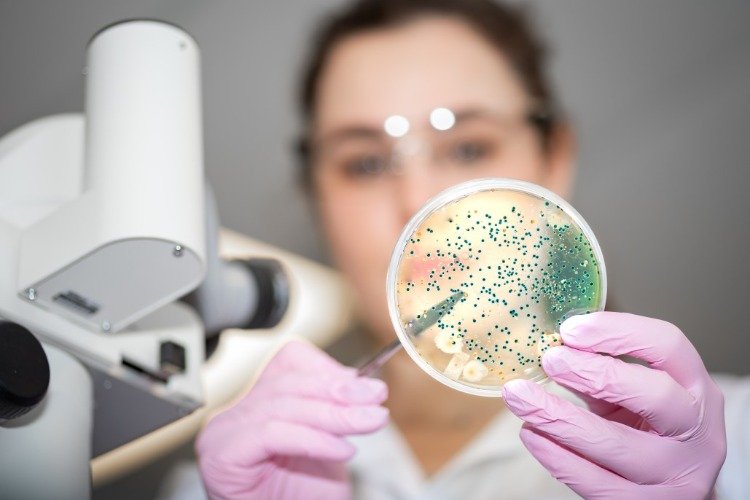
mladý laboratórny technik mikrobiológia a kmeň coli nissle užitočný výskum

E Coli Nissle – Probiotické kmene pre lepší črevný mikrobióm
Podľa nového výskumu sa ukázalo, že E Coli Nissle, kmeň Escherichia coli, je neškodný pre črevné tkanivá. Tieto probiotické kmene môžu navyše chrániť črevá pred enterohemoragickou E. coli (EHEC). Ten je patogénom, ktorý produkuje toxín Shiga. E. coli má zlý rap, pretože niektoré patogénne kmene môžu spôsobiť vážne až život ohrozujúce symptómy. Komenzálny kmeň E Coli Nissle sa používa ako probiotikum viac ako storočie a v poslednej dobe sa používa na liečbu črevných porúch vrátane ulceróznej kolitídy.
Dobré črevné baktérie kmeňa E Coli Nissle
Vedci z University of Cincinnati chceli pochopiť, či tento kmeň baktérií môže chrániť aj črevné tkanivo pred EHEC a inými patogénmi. Študovali ochranné účinky probiotika pomocou ľudských črevných organoidov, ktoré sú experimentálnymi modelmi skutočného tkaniva pochádzajúceho z kmeňových buniek. Vedci najskôr vpichli organoidy E Coli Nissle a zistili, že baktéria je neškodná. Nepoškodilo epiteliálnu bariéru tvorenú ochrannou vonkajšou vrstvou organoidu. Ďalej v oddelených experimentoch injekčne podali organoidy z enterohemoragickej E. coli. Tento patogén produkuje toxín Shiga, ktorý milióny ľudí ochorie a dokonca každoročne zabije tisíce ľudí, väčšinou detí. EHEC potom rýchlo porušil epiteliálnu bariéru v organoidoch.

Potom vedci predbežne ošetrili črevné tkanivo E Coli Nissle a injekčne podali EHEC o 12 hodín neskôr. Tu sa kmeň E. coli Nissle v roku 1917 ukázal ako ochranný. Aj keď sa EHEC v tkanive zvýšil, nezničil epiteliálnu bariéru. V tom istom čase populácia Nissle v tkanive rýchlo klesala. Vedci zistili rovnaké účinky, keď im do vopred upraveného črevného tkaniva vstrekli uropatogénnu E. coli. Toto je kmeň, ktorý je zodpovedný za väčšinu infekcií močových ciest. V zásade bol Nissle zabitý patogénnymi baktériami, ale to umožnilo črevu lepšie odolávať poškodeniu.
Sľubné výsledky výskumu

Výsledky naznačujú, že kmeň E Coli Nissle môže ponúkať výhody tým, že priamo neinhibuje patogénne kmene. Baktéria namiesto toho používa obranné mechanizmy v samotnej bunke. Prírodné probiotikum teda môže pomôcť predchádzať závažným infekciám EHEC. Výsledky však tiež naznačujú, že Nissle môže byť náchylný na fág z toxínu Shiga. To by obmedzilo užitočnosť probiotika ako terapeutika. Vedci tiež varujú, že na lepšie pochopenie komplexných interakcií bakteriálnych druhov v prostredí skutočného sveta sú potrebné ďalšie štúdie.

Výskum sa zameriava na baktérie, ktoré produkujú toxín Shiga, napríklad EHEC. Akonáhle deti dostanú EHEC, lekári im môžu dávať iba tekutiny a podporovať ich. Z tohto dôvodu sú výskumníci týmto Potenciál štúdie nadšený. To môže slúžiť ako model pre lepšie pochopenie črevného mikrobiómu a je to zásadný prielom. Mnoho takýchto patogénov je špecifických a organoidy sú veľmi užitočné pri štúdiu raných udalostí. Organoidy tiež ponúkajú aspoň jednu ďalšiu zásadnú výhodu oproti myšiam. Laboratórne myši nie sú na takéto skúmanie vhodné.
